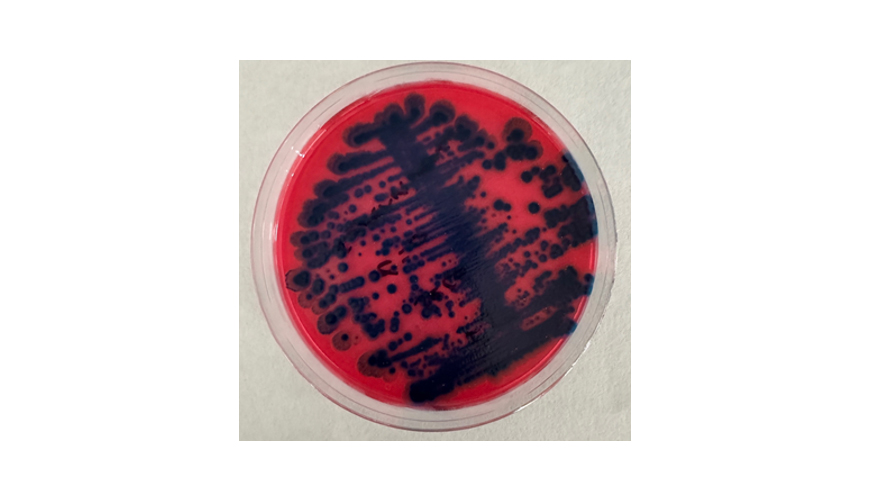
Figura 2. Evaluacin de supervivencia. Presencia de B. thuringiensis

AIMPLAS
Desarrollo de nuevos productos de plasticultura incorporando probióticos (microorganismos) para su uso como insumos
Chelo Escrig, investigadora líder en Agricultura y Medio Acuático
Celia Sevilla, investigadora en Liberación Controlada y Calidad del Suelo
13/06/2025El proyecto BIOENCAPSULACIÓ 2 surge como continuación del proyecto previo BIOENCAPSULACIÓ, siguiendo con la necesidad de reducir la utilización de productos químicos en agricultura, mediante la reducción de productos fertilizantes convencionales y disminución del uso de productos fitosanitarios químicos para el control de plagas en los cultivos agrícolas.

Ante esta problemática, surge el proyecto BIOENCAPSULACIÓ 2, cuyo objetivo principal es continuar trabajando con probióticos ambientales como fertilizantes e incorporar microorganismos con efecto fitosanitario en nuevos productos de plasticultura para que durante el uso de éstos y al final de su vida útil actúen en el control de las plagas.
Por todo lo mencionado, el presente proyecto está relacionado de forma directa con aspectos fundamentales para la sociedad como son la reducción de insumos químicos, la seguridad alimentaria, la contaminación del medio y la eficiencia en su consumo, alineándose con la Política Agraria Común (PAC) de la Unión Europea que fomenta una agricultura ecológica y sostenible mediante la reducción de insumos químicos convencionales.
El proyecto está financiado por el Instituto Valenciano de la Competitividad e Innovación (IVACE+i) y cuenta con la colaboración de empresas como PICDA y la Cooperativa de Llíria.

Hidrogeles funcionalizados
Desarrollo de hidrogeles mediante la combinación de polímeros naturales biodegradables, funcionalizados con microorganismos como sustancias activas autorizadas para su uso como fitosanitario y con capacidad de retención de la humedad del suelo. Este producto de plasticultura ofrece un entorno ideal para el aporte de microorganismos durante su vida útil mediante liberación sostenida.
Para este desarrollo se ha empleado Bacillus thuringiensis, puesto que durante la esporulación producen cristales proteínicos que poseen propiedades insecticidas, utilizándose como una alternativa biológica plaguicida. Durante este proyecto, se ha evaluado la supervivencia y liberación de B. thuringiensis incorporado en los hidrogeles realizando un estudio de su liberación y viabilidad durante un periodo de tiempo.
Tabla 1. Resultados de liberación sostenida de B. thuringiensis en hidrogeles (UFC).

El número de microorganismos viables dentro del hidrogel se mantuvo estable durante el periodo de tiempo estudiado, siendo la concentración inicial de la disolución bacteriana esporulada 5.0 105. Se observa presencia de dichos microorganismos por un procedimiento adicional de evaluación de supervivencia que consiste en inocular la muestra liberada en un medio que favorece su crecimiento y posterior siembra en placa (ver figura 2).
Figura 2. Evaluación de supervivencia. Presencia de B. thuringiensis.
Estos hidrogeles hidrofílicos desarrollados presentan capacidad de retención de la humedad del suelo con tendencia ascendente a medida que las cápsulas se rehidratan, mostrando capacidad de absorción de agua con un mínimo de 30 ciclos de rehidratación. La metodología de obtención ha sido optimizada para, posteriormente, realizar un escalado con un equipo de laboratorio con el objetivo de automatizar y aumentar la producción.
Adicionalmente, se han evaluado los posibles efectos ecotoxicológicos del hidrogel en diferentes plantas superiores en base a lo establecido en la Norma UNE-EN-17033 y guía OECD 208. Los resultados obtenidos confirman la ausencia de efectos ecotoxicológicos adversos del hidrogel funcionalizado. Al mismo tiempo, se está evaluando su biodegradabilidad en suelo, siguiendo los requisitos de la Norma UNE-EN-17033 que especifica los métodos de prueba y los criterios de evaluación relacionados con la biodegradación.
Aunque el estudio de biodegradabilidad se encuentra en curso, los resultados obtenidos hasta el momento muestran una tendencia favorable en cuanto a la biodegradabilidad del hidrogel, como se muestra en la siguiente figura. Nótese que la duración de estos ensayos es de 48 meses, y en la Figura 3, se muestra una biodegradación de casi el 50% en un periodo inferior a 6 meses.

Tabletas funcionalizadas
Desarrollo de tabletas monodosis funcionalizadas empleando biopolímeros y sustratos naturales mediante la incorporación de microorganismos, tanto con efecto bioestimulante como fitosanitario, que se incorporan en el suelo para mejorar la eficiencia y producción durante la plantación y el desarrollo de los cultivos. Al igual que el producto mencionado anteriormente, estos comprimidos ofrecen un medio favorable para el aporte de microorganismos durante su vida útil mediante liberación sostenida.
Para este desarrollo se ha empleado Bacillus thuringiensis y Azospirillum brasilense, utilizándose este último como una alternativa biológica fertilizante. Durante el proyecto, se está evaluando la supervivencia y liberación de ambos microorganismos incorporados en las tabletas realizando un estudio de su liberación y viabilidad durante un periodo de tiempo.
Tabla 2. Resultados de liberación sostenida de B. thuringiensis en tabletas (UFC).

Respecto B. thuringiensis, el número de esporas viables dentro de la tableta se mantuvo estable durante el periodo de tiempo estudiado, siendo la concentración inicial de la disolución bacteriana esporulada 1,2 106 UFC/ml. Se produce una liberación sostenida de las esporas, presentando la tableta propiedades que permiten una liberación sostenida de esporas bacterianas a una tasa constante, como se observa en la tabla anterior.
Tabla 3. Resultados de liberación sostenida de A. brasilense en tabletas (UFC).

En cuanto A. brasilense, se observa la viabilidad de los microorganismos tras su incorporación en la tableta, siendo la concentración inicial de la disolución bacteriana 8.4 108 UFC/ml. Se produce una liberación sostenida de las células bacterianas, y al igual que la otra tableta desarrollada, estas presentan las propiedades adecuadas para mantener la viabilidad de las células bacterianas y su liberación a una tasa constante.
La metodología de obtención de estas tabletas ha sido optimizada a nivel laboratorio mediante una tableteadora manual para, posteriormente, realizar un escalado a nivel planta piloto mediante una tableteadora automática con el objetivo de automatizar y aumentar la producción de dicho producto. A su vez, se ha realizado una experimental incorporando ambas tabletas a un sustrato suelo determinándose los efectos ecotoxicológicos y el efecto en el rendimiento en diferentes plantas superiores en base a lo establecido en la guía OECD 208. Los ensayos han mostrado resultados favorables respecto al blanco, confirmando la ausencia de efectos ecotoxicológicos adversos.
De forma paralela a estos estudios, tras realizar el escalado de ambos desarrollos, se está realizando un ensayo directo en condiciones semicontroladas de campo para evaluar la efectividad de los desarrollos: hidrogeles funcionalizados con efecto fitosanitario y tabletas funcionalizadas con efecto bioestimulante, en cultivo de pimiento. Durante este ensayo, se estudia cómo los productos desarrollados afectan en el rendimiento del cultivo (germinación, biomasa, fruto y control de plaga). Esta experimental comenzó el pasado 5 de mayo y tendrá una duración de aproximadamente 3 meses hasta la obtención del fruto. Tras la finalización de la experimental se evaluará la calidad del fruto de forma comparativa. Las siguientes imágenes muestran la experimental que se está llevando a cabo.

Figura 4. Experimental con demostradores en condiciones semicontroladas de campo: Control (Demostrador 1), Hidrogeles fitosanitarios (Demostrador 2), Tabletas bioestimulantes (Demostrador 3).






























